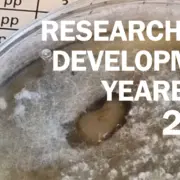

STERF now also on YouTube!
Check out STERF on LinkedIn and YouTube
Invitation – NIBIO Field Day in Lüneburg, Germany
Field day, September 23-24th, Lüneburg, Germany
Voices from the ITRC 2025 Conference in Japan
Voices from the ITRC 2025 in Japan
Call for proposals
Call for proposals 2026-28 – Apply now!
Article from SCANGREEN 2023-26
Midway results from SCANGREEN 2023-26
Video interviews from the field day at Hirsala Golf
Video interviews from the field day at Hirsala Golf
New seed lists available!
New seed lists available!
Field day and Project update
26TH JUNE 2025, at Hirsala Golf, Finland
Results from ADORE
Can artificial intelligence (AI) help golf course managers?
International Turfgrass Field Day – September 9th, 2025
The International Turfgrass Field Day
The STERF Annual Yearbook 2024
Read about important events and running research projects.
Four new Research Programmes
New international and trans-disciplinary R&D programmes
New article from the project FAIR WATER II
New article from the project FAIR WATER II
Revised Winter survival fact sheet – Re-establishment
Revised factsheet about re-establishment after winter damage
ICE-BREAKER Final project report
ICE-BREAKER final project report
Revised Winter survival fact sheet – Spring stresses
Revised factsheet about spring stresses.
New articles from FAIRWATER and SCANGREEN
New articles from FAIRWATER and SCANGREEN
Interview with STERF’s chairman on status and challenges
STERF´s chairman, Bruno Hedlund, talks about the current situation in the turf area, challenges ahead and what he is most proud of with STERF´s journey so far. Eleven minutes filmed interview at Sisjö GC in Västra Frölunda, Gothenburg, Sweden.
View it at klubbtv.nu
A lot of material!
We will be uploading more information every week and encourage you to continuously visit us.
Article on grasses winter tolerance
News from the ICE-BREAKER project on how tolerant different turfgrass species and varieties are to ice encasement.
ITRI are requesting proposals
International Turfgrass Research Initiative´s (ITRI) request for proposals. Deadline for pre-proposals are due August 15th 2024.
Grass species and varieties for severe winter climates
This updated fact sheet will help you choose the most winter hardy grass species and varieties when establishing, re-seeding, or over-seeding golf courses or other turfgrass areas in the Nordic countries.
International Turfgrass Research Initiative launched to advance worldwide sustainability in golf
STERF, The R&A, and the USGA have launched the International Turfgrass Research Initiative to further the advancement of sustainable approaches to golf course and turfgrass management.
IPM-project Final report
Read all about the Integrated Pest Management project, from start to finish, and the final results that have been presented
The STERF Annual Yearbook 2023
Read about important events during the year and find describtions of all running and recently finished research projects.
FACT SHEET – Use of robotic mowers on golf courses
This fact sheet will guide you through the newest knowledge on the use of small lightweight robotic mowers on golf course fairways and semi-roughs.